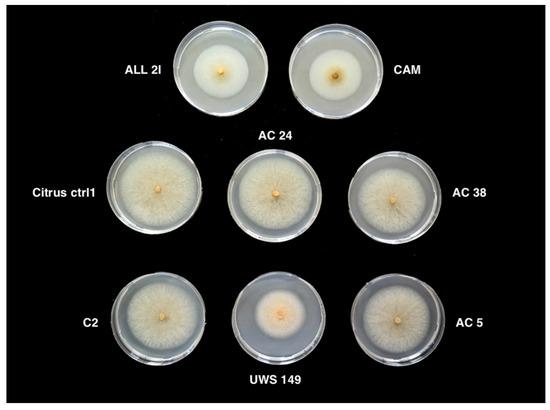

Abstract
(1) Background: This study was aimed at identifying the Colletotrichum species associated with twig and shoot dieback of citrus, a new syndrome occurring in the Mediterranean region and also reported as emerging in California. (2) Methods: Overall, 119 Colletotrichum isolates were characterized. They were recovered from symptomatic trees of sweet orange, mandarin and mandarin-like fruits during a survey of citrus groves in Albania and Sicily (southern Italy). (3) Results: The isolates were grouped into two distinct morphotypes. The grouping of isolates was supported by phylogenetic sequence analysis of two genetic markers, the internal transcribed spacer regions of rDNA (ITS) and β-tubulin (TUB2). The groups were identified as Colletotrichum gloeosporioides and C. karstii, respectively. The former accounted for more than 91% of isolates, while the latter was retrieved only occasionally in Sicily. Both species induced symptoms on artificially wound inoculated twigs. C. gloeosporioides was more aggressive than of C. karstii. Winds and prolonged drought were the factor predisposing to Colletotrichum twig and shoot dieback. (4) Conclusions: This is the first report of C. gloeosporioides and C. karstii as causal agents of twig and shoot dieback disease in the Mediterranean region and the first report of C. gloeosporioides as a citrus pathogen in Albania.
1. Introduction
Albania with around 2000 ha of citrus groves is a relatively small citrus growing country, but has an old tradition in the production of citrus, primarily represented by mandarins and prevalently concentrated in the districts of Vlorë, Berat, Elbasan, Durrës, Tiranë, Lezhë, Shkodër and Gjirokastër [1]. Italy ranks second among European citrus producer countries, with Sicily and Calabria regions (southern Italy) accounting for approximately 63 and 19% of total domestic production of oranges and 53 and 20% of production of tangerines, respectively [2]. Sicily alone accounts for around 86% of total domestic production of lemons [2]. Moreover, Italy is the leading producer country of organic citrus fruit globally, with over 35,000 ha, corresponding to about one third of the total domestic citrus growing area [3]. Over the last years in both Albania and southern Italy, outbreaks of citrus twig and shoot dieback were observed to occur in major orange and mandarin growing areas following extreme weather events whose frequency in the Mediterranean region has increased due to climate change [4]. The disease, here named twig and shoot dieback of citrus or Colletotrichum twig and shoot dieback to stress its association with pathogenic Colletotrichum species, was recently described as an emerging new disease of citrus in Central Valley, California, distinct from the typical anthracnose of fruit, leaves and twigs [5,6]. Symptoms of dieback caused by Colletotrichum included chlorosis, crown thinning, necrotic blotches on leaves, blight and frequently gummosis of apical twigs, shoot and branch dieback [6]. Two Colletotrichum species, C. gloeosporioides and C. karstii, were associated with Colletotrichum dieback in California. Overall, neither species clearly prevailed over the other and, in pathogenicity tests, both species were able to infect twigs, although not all field symptoms were reproduced [5]. In pathogenicity tests performed in California, C. karstii was more aggressive than C. gloeosporioides [5]. Symptoms similar to twig and shoot dieback described in California were reported from countries of the Mediterranean region, including Algeria, Marocco and Tunisia, but they were always associated with other symptoms typical of anthracnose on fruits and leaves [7,8,9]. In a recent survey of citrus groves in Portugal aimed at identifying the Colletotrichum species associated with typical anthracnose on fruits, leaves and twigs, C. gloeosporioides, the dominant species, was isolated preferentially from fruits and leaves while C. karstii was isolated preferentially from twigs and leaves, suggesting the hypothesis of differences in host-plant organ specificity between these two species [10]. Differences in host-plant organ preference between Colletotrichum species complex have long been known [11]. Two of the best-known examples of host and organ specificity are provided by C. abscissum and C. limetticola, both in the C. acutaum complex, associated to post-bloom fruit drop (PFD) of citrus and Key Lime Anthracnose (KLA), respectively, occurring in the Americas [12,13,14,15,16]. According to the new molecular taxonomy of the genus Colletotrichum, based on multi-locus phylogeny and a polyphasic approach, 25 distinct Colletotrichum species have been so far identified to be associated to Citrus and allied genera worldwide. Seven of these, including C. aenigma, C. ciggaro (syn. C. kahawae subsp. ciggaro), C. gloeosporioides sensu stricto (s.s.) and C. hystricis, within the C. gloeosporioides species complex, C. catinaense and C. karstii, within the C. boninense species complex, and C. acutatum s.s., within the C. acutatum species complex, have been reported from Italy [9,10,17,18,19,20,21,22,23,24,25,26,27,28], while in the literature there is no record of Colletotrichum infecting citrus from Albania. The objectives of this study were to identify the Colletotrichum species associated with the new disease twig and shoot dieback or Colletotrichum twig and shoot dieback of citrus in Albania and Sicily and evaluate the pathogenicity of these Colletotrichum species on different plant organs, including fruit, leaves and shoots.
2. Materials and Methods
2.1. Sampling and Isolation
During 2017 and 2018, citrus orchards were surveyed for twig and shoot dieback in six municipalities (Augusta, Lentini, Mineo, Misterbianco, Ramacca and Scordia) of the provinces of Catania and Syracuse (Sicily, southern Italy), and in the municipality of Xarrë, prefecture of Vlorë (Vlorë, Albania). Colletotrichum isolates were obtained from twigs with symptoms of blight and gumming and from leaves showing necrotic patches and mesophyll collapse. Overall, samples were collected from 10 citrus groves in Albania and six citrus groves (one for each municipality) in Sicily and from diverse citrus species and cultivars, including Clementine mandarin (Citrus x clementina), three cultivars of sweet orange (Citrus × sinensis), “Tarocco Lempso”, ‘Tarocco Scirè’ and “Lane Late”, and two mandarin-like hybrids, “Fortune” (C. × clementina × “Orlando” tangelo) and “Mandared” (C. × clementina “Nules” × C. × sinensis “Tarocco”).
To obtain fungal isolates, twig and leaf fragments (5 mm) were washed with tap water, surface sterilised with a sodium hypochlorite solution (10%) for 1 min, immersed in 70% ethanol for 30 s and rinsed in sterile distilled water (s.d.w.). After disinfection, the fragments were blotted dry on sterilised filter paper, placed in Petri dishes on potato-dextrose-agar (PDA; Oxoid Ltd., Basingstoke, UK) amended with 150 μg/mL streptomycin and incubated at 25 °C until typical Colletotrichum colonies were observed. Sporulating conidiomata from subcultures were collected, crushed in a drop of s.d.w. and spread in Petri dishes over the surface of PDA amended with streptomycin to obtain single-conidium isolates. After 24 h incubation at 25 °C, germinating conidia were individually transferred to Petri dishes onto PDA. Stock cultures of single-conidium isolates were mantained on PDA slants under mineral oil at 5–10 °C in the culture collection of the Molecular Plant Pathology laboratory of the Department of Agriculture, Food and Environment of the University of Catania, Italy.
2.2. Fungal Isolates
A total of 119 single-conidium isolates of Colletotrichum from citrus, representing a population of mass isolates around ten-fold larger, was characterised in this study (Table 1).

Table 1.
Isolates of Colletotrichum sourced from different cultivars of Citrus species in Sicily (southern Italy) and Albania and characterized in this study. * Tetraploid hybrid clementine ‘Nules’x sweet orange ‘Tarocco’.
Mass isolates were obtained from symptomatic twigs and leaves and were preliminarily separated into two groups on the basis of morphotype, i.e., colony morphology, radial growth rate on PDA at 25 °C and microscopical traits, such as the shape and size of conidia and the presence of setae. About 10% of mass isolates of each morphotype and from each site were selected randomly and a single-conidium isolate was obtained from each selected mass isolate. A C. acutatum s.s. isolate (UWS 149) from olive (Olea europaea) sourced in Australia and a C. gloeosporioides s.s. isolate (C2) from lemon (Citrus × limon), sourced in Calabria [29], as well as a C. karstii (CAM) from Camellia sp., sourced in Sicily [26], were used as references in growth and pathogenicity tests.
2.3. Morphological Characteristics and Optimum Growth Temperature of Isolates
Agar plugs (5-mm-diam) were taken from the edge of actively growing cultures on PDA and transferred to the centre of 9-cm diameter Petri dishes containing PDA. Dishes were incubated at 25 °C either in the dark for 10 d to determine both the colony morphology and radial growth rate or with continuous fluorescent light to observe microscopical morphological traits. Conidial and mycelial suspensions were prepared in s.d.w. from 10-day-old cultures and examined microscopically.
Optimum temperature for radial growth was determined only for a restricted number of isolates of the two morphotypes and also for isolates of C. acutatum (UWS 149), C. gloeosporioides (C2) and C. karstii (CAM) used as references. Agar plugs (5-mm-diam) were taken from the edge of actively growing cultures on PDA and transferred to the centre of 9-cm diameter Petri dishes containing PDA. Dishes were incubated at 20, 25 and 30 °C in the dark (three replicates per each temperature and per each isolate). Two orthogonal diameters were measured per each colony after 3 and 7 d incubation. The experiment was repeated once with similar results, so results of only one experiment are reported.
2.4. DNA Extraction, PCR Amplification and Sequencing
Genomic DNA was extracted from single-conidium Colletotrichum isolates using the method described in Cacciola et al. [30]. The ITS1–58S–ITS2 region and the fragment of the β-tubulin 2 gene (TUB2) between exons 2 and 6 were amplified and sequenced from a complete panel of isolates as described in a previous paper [30]. Amplified products were analyzed by electrophoresis and single bands of the expected size were purified with the QIAquick PCR Purification Kit (Qiagen, Hilden, Germany) and sequenced with both forward and reverse primers by Macrogen Europe (Amsterdam, The Netherlands). The ChromasPro v. 1.5 software [31] was used to evaluate the reliability of sequences and to create consensus sequences. Unreliable sequences in which both forward and reverse sequences, or one or the other, were not successful or contained doubtful bases were re-sequenced. The ITS and TUB2 sequences obtained in the present study were deposited in GenBank and the relative accession numbers are reported in Table 1. Validated sequences representative of all species identified within the C. boninense and C. gloeosporioides species complexes were phylogenetically analysed to determine the relationship between different isolates and define their taxonomic status. Sequences from ex-type or authentic culture were included in the analysis as a reference (Table 2).

Table 2.
GenBank accession numbers of sequences of the isolates of worldwide origin used as references in phylogenetic analyses.
Phylogenetic analysis was conducted for the ITS and TUB2 sequences, as well as for the combined data set of the two markers using maximum likelihood and Bayesian methods. TOPALi v2 [37] was used to determine the substitution model that best fitted the data. The model HKY + I + G was selected for the Bayesian and maximum likelihood phylogenetic analysis using MrBayes v. 3.1.1 and PhyML v. 2.4.5, respectively, implemented in TOPALi. Bayesian analysis was performed with four runs conducted simultaneously for 500,000 generations with 10% sampling frequency and burn-in of 30%. Maximum likelihood was performed with 100 bootstrap replicates.
2.5. Pathogenicity Test
The pathogenicity of all 119 single-conidium isolates of Colletotrichum from citrus and the reference isolates of C. acutatum, C. gloeosporioides and C. karstii was tested on mature apple fruits (Malus domestica) ‘Fuji’ and ‘Cripps Pink’. The assay on apples was included in this study as it was often used as a standard method to evaluate the pathogenicity of Colletotrichum spp. from various host-plants [38]. Apples (three apples per fungal isolate) were wound inoculated by removing aseptically a piece of tissue (3 mm side) using a scalpel, then inserting a mycelim plug of the same size upside down into the pulp of the fruit and putting back in place the piece of tissue. A sterile agar plug was inserted into control apples. Apples were incubated at 25 °C and the area of the external lesion was measured seven days post inoculation (d.p.i.). In a preliminary test using a set of isolates, including the reference isolates of C. acutatum (UW 149), C. gloeosporioides (C2) and C. karstii (CAM), no difference in susceptibility was observed between ‘Fuji’ and ‘Cripps Pink’ apples, so in subsequent tests of the 119 Colletotrichum isolates sourced from citrus during the survey and the reference isolates of the three Colletotrichum species fruits of the two apple cultivars were used indifferently depending on the availability.
The pathogenicity of a more restricted subset of isolates, including four C. gloeosporioides isolates from citrus (one, Citrus ctrl 1, sourced in Albania, and three, AC5 and AC24 from twigs and AC38 from leaf, sourced in Italy) two C. karstii isolates (ALL2I and ALL2S sourced in Italy) and the reference isolates of C. acutatum from olive (UWS 149), C. gloeosporioides (C2) from lemon and C. karstii (CAM) from camellia, was tested on different citrus plant organs, including young twigs of sweet orange ‘Tarocco Scirè’, lemon (C. × limon) ‘Femminello 2Kr’ and bergamot (C. × bergamia) ‘Fantastico’, young and mature expanded leaves of sweet orange ‘Moro’ and ‘Navelina’, mature fruit of sweet orange ‘Tarocco Meli’ and lemon ‘Femminello 2Kr’ as well as green fruitlets of lemon ‘Femminello 2Kr’.
On 1 June 2020, twigs (around 0.5 cm diameter) were wound inoculated using a scalpel to lift a strip of bark and insert under the bark, upside down and in contact with the cambium, a mycelium plug (3 mm side) taken from the edge of an actively growing culture on PDA. A plug of sterile agar was inserted under the bark of control twigs. The wounds were sealed tightly with Parafilm®. Inoculations were carried out on four-year-old trees in an experimental field in the municipality of Mineo. Six twigs on each tree were inoculated and six served as a control. The length of necrotic lesions was recorded at 14 d.p.i. The experimental design was a complete randomized block with three replicates (trees) per each citrus variety and Colletotrichum isolate combination. The experiment was repeated on June 30th and the data of the two experiments were analyzed separately.
The same Colletotrichum isolates were used to inoculate fruits and leaves, to test their ability to produce symptoms of anthracnose. Ripe sweet orange and lemon fruits were surface disinfected with 70% ethanol, rinsed with s.d.w., blotted dry and inoculated by wounding and without wounding. Unwounded fruits were inoculated by putting mycelium plugs (3 mm side) directly on the peel (two plugs on the upper side of each fruit placed horizontally, four cm apart from each other). Control fruits received sterile agar plugs. The same number of fruits was inoculated using a scalpel to remove aseptically two small pieces (3 mm side) of peel, four cm apart from each other. Mycelium plugs of the same size were inserted upside down into the albedo and the peel pieces were replaced to cover the wounds. Sterile agar plugs were inserted into the albedo of control fruits. After inoculation, fruits were placed in humid chambers (plastic boxes with air-tight lid) on plastic rings to avoid direct contact with the humid paper and incubated at 25 °C under 16/8 h light/dark photoperiod and 90% RH. Symptoms were recorded three, six and 12 d.p.i. Four replicated fruits for each inoculation method (wounding and without wounding) and Colletotrichum isolate combination were included in each of the two separate experiments, one with mature sweet orange fruit and the other with mature lemon fruit, respectively. In a separate trial the same Colletotrichum isolates were inoculated on unripe fruitlets of lemon ‘Feminello 2Kr’. Differently from tests on mature fruit, each fruitlet was inoculated with a single plug instead of two. Symptoms were recorded three and six d.p.i.
Expanded young (from summer vegetative flushing) and mature (from spring or previous year vegetative flushing) leaves of sweet orange ‘Moro’ and ‘Navelina’ were collected on 2 October 2020 in the same citrus orchard, surface disinfected with 70% ethanol, washed with s.d.w., blotted dry and transferred to a humid chamber (plastic boxes with air-tight lid) on blotting paper soaked with s.d.w. and covered with aluminium foil to avoid direct contact between leaves and water. Leaves were inoculated on the abaxial side by wounding and without wounding. A razor blade was used to gently scrape the surface of the leaf lamina so as to create small (2 mm side) superficial lesions (six lesions per leaf, three on each side of the midrib). A mycelium plug (3 mm side) taken from the edge of an actively growing culture on PDA was put on each lesion with the side covered by mycelium in contact with the leaf surface. Six mycelium plugs (three on each side of the midrib) were placed on the lamina of unwounded leaves. Sterile agar plugs were placed on both wounded and unwounded leaves used as controls. Leaves were incubated in humid chamber at 25 °C under 16/8 h light/dark photoperiod and 90% RH and symptoms were recorded at five d.p.i. The experimental design was a complete randomized block with four replicates (leaves) for each citrus variety, type of leaf (young or mature), inoculation method (wounded or unwounded) and Colletotrichum isolate combination.
Colletotrichum isolates used in pathogenicity tests were re-isolated from the lesions and identified based on colony morphology to fulfil Koch’s postulates. The identity of the isolates obtained from artificially inoculated symptomatic twigs, fruit and leaves was also confirmed by sequencing the ITS and TUB2 regions.
2.6. Statistical Analysis
Data from pathogenicity tests were analyzed using RStudio v.1.2.5 (R) [39]. The means of surface areas of necrotic lesions induced by different Colletotrichum isolates were compared and analyzed by one-way Analysis of Variance (ANOVA) coupled with Tukey-Kramer Honestly Significant Difference (HSD) test. Likewise, ANOVA and Tukey-Kramer Honestly Significant Difference (HSD) test were applied for statistical analysis of the differences between mean colony diameters in radial growth tests of isolates at different temperatures. When comparing independent groups, Student’s t-test was used. Levene’s test was used to determine the homogeneity of variance between independent trials. No heterogeneity was detected and data from independent trials were combined.
3. Results
In all surveyed orchards, outbreaks of Colletotrichum twig and shoot dieback of citrus were observed from April to October on both young and mature trees and always following strong winds, occurring on trees suffering because of water stress after prolonged drought. Symptoms included blight and gumming of twigs (Figure 1B,C), defoliation and crown thinning as well as necrotic blotches, russeting of the abaxial side and mesophyll collapse of leaves remained still attached to the twigs (Figure 1D). In most severe cases, dieback of entire branches (Figure 1A) and death of young (one- to three-year-old) trees were observed. The incidence of the disease in a single orchard varied greatly irrespective of the age of the trees. In most orchards, affected trees were scattered and only a few twigs or shoots were symptomatic within a tree while in a few orchards more than 80% of trees were more or less seriously affected.

Figure 1.
(A). Shoot blight and dieback of entire branches on Sweet orange ‘Tarocco Scirè’ injured by wind. (B) Symptoms of shoot blight incited by Colletotrichum infections on Sweet orange ‘Tarocco Scirè’ injured by wind. (C) Gumming associated with citrus shoot blight on Sweet orange ‘Tarocco Scirè’. (D) Leaf mesophyll collapse and necrosis caused by wind on leaves of ‘Tarocco Scirè’ sweet orange. Conidiomata of Colletotrichum are visible on necrotic lesions as black pin point-dots.
Symptoms were often severe on the top of the canopy of mature trees and on trees exposed to wind and suffering because of drought. Overall, about 1200 Colletotrichum isolates were sourced in Sicily, 93% from twigs and 7% from leaves. About 180 isolates were sourced in Albania, all from twigs. All the isolates from Albania showed the same morphology.
Colonies of these isolates on PDA were low-convex, fast-growing (10–11 mm average growth per day at 25 °C), with entire margin and dense, cottony, aerial mycelium, initially white turning to pale grey and salmon pink conidial mucilaginous masses in the centre of the colony, dark acervuli scattered over all the surface in old colonies. Colony reverse was pale orange to uniformly grey. Single-celled conidia were, hyaline, smooth, cylindrical with both ends rounded; the range of their dimensions was 11–15 × 4–6 μm. Setae were common in most isolates. Conversely, Colletotrichum isolates from Italy were separated into two clearly distinct groups on the basis of morphotype (Figure 2). The first group, encompassing the majority of isolates and including isolates from both twigs and leaves, showed the same morphotype as isolates from Albania. The second group, encompassing about 100 mass isolates from twigs sourced from sweet orange ‘Lane Late’ in the municipality of Augusta, showed a different morphotype. Colonies on PDA were less fast growing (8 mm average growth per day at 25 °C) and flat, with entire margin, mycelium appressed and moderately dense, white-orange to pale gray-orange, minute salmon orange conidium masses scattered over all the surfaces. The colony reverse was pale orange. Conidia were single-celled, hyaline, smooth, cylindrical with both ends rounded; the range of their dimensions was 10–17 × 4–6 μm. Setae were exceedingly rare or absent in most isolates.
Figure 2.
Morphology of 6-day-old colonies of Colletotrichum gloeosporioides (AC24, AC38, AC5, C2 and Citrus ctrl1), C. acutatum (UWS 149) and C. karstii (ALL 2I and CAM) grown on potato-dextrose-agar at 25 °C in the dark.
The phylogenetic analysis of the combined data set of sequences from ITS and TUB2 regions of all single-conidium Colletotrichum isolates from citrus sourced in Albania and southern Italy (Table 1), along with sequences of the isolates of C. acutatum (UWS 149), C. gloeosporioides (C2) and C. karstii (CAM) used as references and the reference sequences of Colletotrichum species separated within the C. gloeosporioides and C. boninense species complexes, produced a phylogenetic tree (Figure 3) with a similar topology and high concordance with those reported by the authors who revised the systematics of these species complexes using multigene sequence analysis [14,22,23].

Figure 3.
Phylogenetic tree obtained using combined internal transcribed spacers (ITS) and β-tubulin (TUB2) sequences of isolates of Colletotrichum spp. collected in the present study along with reference isolates of C. karstii, C. gloeospoiroides, and other representative species of the other Colletotrichum boninense, C. gloeosporioides and C. acutatum species complex. The evolutionary history was inferred using the maximum likelihood method based on the Tamura–Nei model and the tree with the highest log likelihood is shown. The percentage of trees in which the associated taxa clustered together is shown next to the branches.
All the isolates from Albania and the isolates from southern Italy with the same morphotype were identified as C. gloeosporioides because they clustered (bootstrap values 100%) with the ex-type isolate of this species. Conversely, the 10 single-conidium isolates from the municipality of Augusta showing a distinct morphotype clustered (bootstrap values 100%) with ITS and TUB2 region sequences of reference isolates of C. karstii, including the culture from holotype isolate CBS 132134/CORCG6 and the isolate CAM from camellia sourced in Sicily. Sequences of isolates of both C. gloeosporioides and C. karstii were clearly distinct from reference sequences of C. acutatum.
All selected isolates of both C. gloeosporioides and C. karstii as well as the reference isolate of C. acutatum grew faster at 25 than at 30 and 35 °C. However, at 30 and 35 °C the C. gloeosporioides isolates were less inhibited than isolates of the other two species, indicating they were more thermofilic. In particular, the radial growth of C. gloeosporioides isolates at 30 °C was reduced only by 7 to 11% compared to the growth at 25 °C, and by 16 to 30% at 35 °C. Conversely, the growth of C. karstii isolates was reduced by 55 to 60% at 30 °C and by 75 up to 79 % at 35 °C. The growth of the reference isolate of C. acutatum was dramatically reduced at 30 and 35 °C, by 79 and 88% respectively (Table 3).

Table 3.
Mean radial growth rates of colonies of Colletotrichum spp., isolates on PDA at three different temperatures, as determined after 7 d of incubation.
In pathogenicity tests on apples, all isolates were pathogenic. However, symptoms induced on apples by isolates of the three tested Colletotrichum species were different. Necrotic lesions induced by the C. gloeosporioides isolates were dark brown, with a definite margin and black conidiomata emerging from the surface in concentric rings (Figure 4A).

Figure 4.
(A) Necrotic lesion induced by a Colletotrichum gloeosporioides isolate on a wound inoculated apple seven d.p.i. (B) Necrotic lesion induced by the Colletotrichum acutatum reference isolate on a wound inoculated apple seven d.p.i. (C) Necrotic lesion induced by a Colletotrichum karstii isolate on a wound inoculated apple seven d.p.i.
Lesions induced by the C. acutatum isolate were pale brown with an irregular margin, a faint white aerial mycelium around the inoculation wound and point-like orange masses of conidia scattered over the surface of the lesion (Figure 4B). Lesions on apples inoculated with C. karstii isolates were restricted, dark brown with a faint white mycelim emerging from the wound and without sign of sporulation (Figure 4C). No significant difference in virulence was found between isolates of the same species irrespective of their origin, so data of all isolates belonging to the same species were pooled together. C. gloeosporioides isolates and the reference isolate of C. acutatum were significantly more virulent than isolates of C. karstii (Figure 5).

Figure 5.
Mean area (± SD) of necrotic lesions (mm2) induced by Colletotrichum gloeosporioides (GLO), C. karstii (KAR) and C. acutatum (ACU) isolates on wound inoculated apples, seven d.p.i. Values sharing same letters are not statistically different according to Tukey’s honestly significant difference (HSD) test (p ≤ 0.05).
In in-field tests on twigs of sweet orange, lemon and bergamot the isolates of C. gloeosporioides and C. acutatum were more aggressive than isolates of C. karstii. Isolates of C. acutatum and C. gloeosporioides induced gumming in twigs of all three citrus species while isolates of C. karstii induced gumming only in bergamot twigs (Figure 6A–C).

Figure 6.
(A) Gumming on a twig of lemon ‘Femminello 2Kr’ wound inoculated with a Colletotrichum gloeosporioides isolate 14 d.p.i. (B) Gumming on a twig of bergamot ‘Fantastico’ wound inoculated with a Colletotrichum gloeosporioides isolate 14 d.p.i. (C) Twigs of bergamot ‘Fantastico’ wound inoculated with Colletotrichum karstii (left) and C. gloeosprioides (right) 14 d.p.i. The bark was removed to show the internal symptoms: the twig on the left shows a gum impregnation of the young xylem and a cicatricial tissue around the inoculation point while the twig on the right shows a profuse gumming extending beyond the inoculation point.
Mean length of necrotic lesion of the bark induced by the C. gloeosporioides and C. acutatum isolates was significantly higher than the length of lesions induced by the C. karstii isolates (Figure 7). In twigs inoculated with C. karstii isolates, the necrotic lesion was localized around the inoculation point and the wound healed rapidly. No significant difference in lesion size was observed between sweet orange, lemon and bergamot twigs. Likewise, no significant difference in virulence, as determined on the basis of the size of the necrotic lesion, was observed between isolates of the same Colletotrichum species so data of all isolates belonging to the same species were pooled together. On control twigs, inoculation wounds healed rapidly without any symptoms of necrosis or gummosis.

Figure 7.
Mean length (mm) of necrotic lesions of six twigs per each of three replicated trees (±SD) induced by isolates of Colletotrichum gloeosporioides (GLO) (five isolates, means of 90 replicates), C. karstii (KAR) (three isolates, means of 54 replicates) and C. acutatum(ACU) (one isolate, means of 18 replicates) on in-field artificially inoculated twigs of sweet orange ‘Tarocco Scirè VCR’, lemon ‘Femminello 2Kr’ and bergamot ‘Fantastico’, 14 d.p.i. Values sharing same letters are not statistically different according to Tukey’s honestly significant difference (HSD) test (p ≤ 0.05).
In tests on green and mature fruit as well as on tender and mature leaves Colletotrichum isolates were able to induce lesions only after wounding. In pathogenicity tests on mature fruit of sweet orange and lemon, C. gloeosporioides isolates were more aggressive than isolates of C. karstii even on fruits. Isolates of both species induced a brown necrotic halo around the inoculation wound and the necrosis extended deep into the albedo (Figure 8A,B), but the mean size of lesions induced by the C. gloeosporioides isolates was greater than the mean size of lesions induced by the C. karstii isolates on both sweet orange and lemon (Figure 9). No significant difference in virulence, as determined based on the average size of the necrotic lesion, was observed between isolates of the same Colletotrichum species so data of isolates belonging to the same species were pooled together (Figure 9).

Figure 8.
(A) Necrotic lesions around the inoculation point in a fruit of sweet orange ‘Tarocco Meli’ wound inoculated with an isolate of Colletotrichum gloeosporioides 12 d.p.i.; the peel has been removed to show that the necrosis extends into the albedo. (B) Necrotic lesions around the inoculation point in a fruit of lemon ‘Femminello 2Kr’ wound inoculated with an isolate of Colletotrichum gloeosporioides 12 d.p.i.; the peel has been removed to show that the necrosis extends into the albedo. (C) Aerial mycelium developed on the two inoculation points in a fruit of sweet orange ‘Tarocco Meli’ wound inoculated with the reference isolate of Colletotrichum acutatum 12 d.p.i.; the peel has been removed to show the necrotic lesion extending into the albedo lined by an orange coloured cicatricial tissue. (D). Aerial mycelium growing on the two inoculation points in a fruit of lemon ‘Femminello 2Kr’ wound inoculated with the reference isolate of Colletotrichum acutatum 12 d.p.i.; the peel has been removed to show the necrotic lesion extending into the albedo.

Figure 9.
Mean area (mm2) of necrotic lesions (± SD) induced by isolates of Colletotrichum gloeosporioides b (GLO) (five isolates) and C. karstii c (KAR) (three isolates) a on wound inoculated fruits of sweet orange ‘Tarocco Meli’ and lemon ‘Femminello 2Kr’, 12 d.p.i. Values sharing same letters are not statistically different according to Tukey’s honestly significant difference (HSD) test (p ≤ 0.05). a Four fruits for each citrus species and two inoculation wounds per fruit. b Means of 40 replicates. c Means of 24 replicates.
The reference isolate of C. acutatum induced quite peculiar symptoms on both sweet orange and lemon fruit as the inoculation wounds were covered by a white, cottony aerial mycelium, which masked the lesion. The necrosis extended into the albedo and reached its maximum extent 6 d.p.i., but did not expand further (Figure 8C,D).
As a consequence, the area of the external necrotic lesion cannot be measured and direct comparison with isolates of the other two Colletotrichum species was not possible in terms of virulence. No symptoms were observed on control fruits.
On green fruitlets of lemon differences of symptoms induced by isolates of the three Colletotrichum species were almost exclusively qualitative. All C. gloeosporioides and C. karstii isolates induced gumming and a very restricted necrotic lesion around the inoculation point (Figure 10A,C) while fruitlets inoculated with the C. acutatum isolate showed gumming and an abundant white aerial mycelium covering the lesion (Figure 10B). Symptom appeared three d.p.i. and did not evolve further over the next three days. The only symptom on control fruitlets was the necrosis of tissue plug removed temporarily to inoculate the fruitlets and replaced to plug the inoculation wound.

Figure 10.
(A) Aerial gray mycelium and gum exudate on green fruitlets of lemon ‘Femminello 2Kr’ wound inoculated with an isolate of Colletotrichum gloeosporioides 6 d.p.i. (B) Aerial white mycelium and gum exudate on green fruitlets of lemon ‘Femminello 2Kr’ wound inoculated with the reference isolate of Colletotrichum acutatum 6 d.p.i. (C) Aerial gray mycelium and gum exudate on green fruitlets of lemon ‘Femminello 2Kr’ wound inoculated with an isolate of Colletotrichum karstii 6 d.p.i.
All Colletotrichum isolates induced circular necrotic lesions on young leaves of both ‘Navelina’ and ‘Moro’ (Figure 11A–D) while the only symptom induced on mature leaves of these two sweet orange cultivars was a translucid, very restricted dark brown halo around the inoculation point. No symptoms were observed on both young and mature control leaves.

Figure 11.
(A) Necrotic lesions induced by the heterologous Colletotrichum karstii isolate from camellia on wound inoculated young leaves of sweet orange ‘Navelina’ 5 d.p.i. (B) Necrotic lesions induced by the heterologous reference isolate of Colletotrichum acutatum from olive on wound inoculated young leaves of sweet orange ‘Navelina’ 5 d.p.i. (C) Necrotic lesions induced by an isolate of Colletotrichum karstii from citrus on wound inoculated young leaves of sweet orange ‘Moro’ 5 d.p.i. (D) Necrotic lesions induced by an isolate of Colletotrichum gloeosporioides from citrus on wound inoculated young leaves of sweet orange ‘Moro’ 5 d.p.i.
Slight, albeit significant, differences in susceptibility were observed between ‘Moro’ and ‘Navelina’, the latter being more susceptible to the infection of aggressive isolates. There were, in fact, significant differences in virulence among the Colletotrichum isolates tested. Unexpectedly, the two heterologous isolates, i.e., the C. acutatum reference isolate from olive and the C. karstii reference isolate from camellia, were the most aggressive. Both the C. karstii isolates recovered from ‘Lane Late’ showed an intermediate virulence while the C. gloeosporioides isolates were slightly less virulent and did not differ significantly between each other (Figure 12).

Figure 12.
Mean area of 24 replicates (four leaves with six lesions each) of necrotic lesions (mm2) (± SD) incited by isolates of C. gloeosporioides (Citrus ctr1, AC5, AC24, AC38 and C2), C. karstii (All2I, All2S and CAM) and C. acutatum (UWS149) on wound inoculated young leaves of sweet orange ‘Moro’ and ‘Navelina’, five d.p.i. Values sharing same letters are not statistically different according to Tukey’s honestly significant difference (HSD) test (p ≤ 0.05).
4. Discussion
A new disease of citrus, named twig and shoot dieback or Colletotrichum twig and shoot dieback to stress its association with pathogenic Colletotrichum species, and recently observed in California, is reported for the first time from two citrus growing countries of the Mediterranean region, Albania and Italy, where it was found to be quite common and widespread. According to the modern taxonomy of Colletotrichum based prevalently on multilocus sequence phylogeny and consistently with the results obtained in California, the Colletotrichum species associated with twig and shoot dieback of citrus in Albania and Italy were identified as C. gloeosporioides s.s., in the C. gloeosporioides species complex, and C. karstii, in the C. boninense species complex. Colletotrichum gloeosporioides was the only species associated with twig and shoot dieback in Albania and by far the prevalent species associated with this syndrome in Sicily. C. gloeosporioides is reported for the first time as a pathogen of citrus in Albania. Differently from C. gloeosporioides, C. karstii was found only sporadically, accounting for just around one third of the Colletotrichum isolates retrieved from a single sampling site in Sicily. The results of in-field tests provided evidence that both Colletotrichum species were pathogens on twigs of different citrus species, but C. gloeosporioides was more aggressive than C. karstii, indicating the former species was the main causative agent of twig and shoot dieback in surveyed areas. By contrast, in California C. karstii was proved to be more virulent than C. gloeosporioides [5]. To explain this discrepancy one can only speculate that populations of C. gloeosporioides and C. karstii associated to citrus in California are different from populations of these two species from the Mediterranean region. However, no general conclusion can be drawn as in pathogenicity tests performed in California only a single isolate of C. gloeosporioides and a single isolate of C. karstii were compared [5]. In agreement with our results, previous studies aimed at identifying the Colletotrichum species associated to citrus anthracnose in China and Europe, showed that among the Colletotrichum species recovered from citrus groves C. gloeosporioides was the most common and the most virulent on detached citrus fruits [17,25,27]. No significant intraspecific variability in virulence was observed among the isolates of C. gloeosporioides and C. karstii recovered from citrus in Albania and Italy. However, evidence from other studies indicate the pathogenicity of isolates of both C. gloeosporioides and C. karstii may vary even within populations originating from the same host-plant and geographic area. Marked differences in pathogenicity were reported among isolates of C. gloeosporioides from citrus sourced in Tunisia as well as among C. gloeosporioides isolates from olive sourced in Italy [19,26]. In Portugal, an isolate of C. karstii from sweet orange was as virulent as an isolate of C. gloeosporioides from lemon when inoculated on sweet orange fruits and significantly less virulent when inoculated on lemon and mandarin fruits [10]. In this study, all tested isolates of C. gloeosporioides were more aggressive on twigs than isolates of C. karstii irrespective of their origin.
Colletotrichum gloeosporioides, both in a broad (C. gloeosporioides species complex) and in a strict sense (C. gloeosporioides s.s.), has a wide host range and is the most common Colletotrichum species associated to symptoms of citrus anthracnose globally [8,17,23,24,25,40,41,42]. In this study, all isolates of C. gloeosporioides recovered from trees with symptom of twig and shoot dieback in Albania and Sicily were overly aggressive and were able of inducing anthracnose symptoms on fruits and leaves, as well as necrosis and gumming on twigs of different citrus species.
C. karstii is also a polyphagous species and among the species in the C. boninese complex it is the most common and the one reported from a greater number of countries and different geographical areas [14]. In Italy, it was recovered from several host-plants including olive (Olea europaea), and there is evidence of it as a citrus inhabitant in southern Italy since the 1990s [26,43]. In this study, isolates of C. karstii retrieved from citrus were less virulent than isolates of C. gloeosporioides on artificially inoculated fruits and twigs of both sweet orange and lemon. However, isolates of C. karstii from citrus demonstrated to be more virulent than C. gloeosporioides isolates on young leaves of sweet orange. This agrees with previous reports indicating this Colletotrichum species is a common foliar pathogen of citrus [10,23,24,25]. In a previous study aimed at characterizing the Colletotrichum species in the C. gloeosporioides and C. boninense complexes associated with olive anthracnose, C. karstii isolates from olive showed a low level of virulence on olive drupes, suggesting this species was an occasional pathogen on olive [26].
Overall the results of this survey do not support the hypothesis of organ specificity as a factor determining the prevalence of a Colletotrichum species over another in citrus trees affected by twig and shoot dieback. It is likely that the proportion of C. gloeosporioides and C. karstii isolates recovered in this study and the distribution of these two Colletotrichum species in surveyed areas depend on other factors conditioning their fitness and adaptative capacity. In the years following the revision of the systematics of C. gloeosporioides and C. boninense species complexes that led to the segregation of C. karstii as a distinct species within the C. boninense complex, C. karstii has been increasingly reported from several citrus growing countries, including China, Iran, Italy, New Zealand, Portugal, South Africa, Tunisia, Turkey and USA, always in association with other Colletotrichum species, mainly C. gloeosporioides [5,10,19,20,23,24,27,28]. This does not imply necessarily that C. karstii is an emerging pathogen sensu [4]. It seems more likely that the proliferation of reports of this Colletotrichum species on citrus from diverse and distant geographical areas is a consequence of the taxonomic revision of the C. gloeosporioides and C. boninense species complexes based on multilocus phylogenetic analysis, which provided a framework for a correct identification of already present cryptic species.
In the present study, a third Colletotrichum species included as a reference, C. acutatum s.s., was shown to be as virulent as C. gloeosporioides on artificially inoculated twigs of different citrus species while on fruits of sweet orange and lemon induced symptoms different from the typical anthracnose. Interestingly, shoot blight is one of the symptoms of KLA, a disease caused by C. limetticola, also a species in the C. acutatum complex and affecting exclusively Key lime [14,44]. The only report of C. acutatum s.s. on citrus in Europe is from a small island of the Aeolian archipelago, north of Sicily, where it was recovered from leaves of lemon and sweet orange [17]. Yet this polyphagous Colletotrichum species, probably originating from the southern hemisphere, is already established in southern Italy on different host-plants and is replacing C. godetiae (syn. C. clavatum) as the main causal agent of olive anthracnose in Calabria [45,46,47]. In addition, there is evidence of its presence on oleander in Sicily since 2001 [29]. The threat posed by this exotic Colletotrichum species as a potential citrus pathogen in the Mediterranean region deserves particular attention.
The sudden outbreak of twig and shoot dieback in vast areas following winds and prolonged drought presupposes an inoculum already present and widespread throughout the citrus orchards. As a matter of fact, Colletotrichum gloeosporioides and C. karstii, like many other Colletotrichum species, may have different lifestyles. They may be latent pathogens, endophytes, epiphytes or saprobes and switch to a pathogenic lifestyle when host plants are under stress [48]. As stress factors have a fundamental role in triggering the infection by Colletotrichum species, twig and shoot dieback may be regarded as a complex disease, a definition also encompassing other emerging citrus diseases, such as dry root rot incited by species of Fusarium s.l. [49,50,51]. A common feature of this type of diseases is the difficulty in reproducing the syndrome in experimental conditions as even wounding may only partially substitute environmental stresses and cannot reproduce alone the effects of different stressors acting simultaneously on host-plant. This may explain the failure in reproducing all field symptoms of Colletotrichum twig and shoot dieback by artificial inoculations [5].
5. Conclusions
This study provided evidence that the new disease of citrus named twig and shoot dieback emerging in the Mediterranean region is caused by Colletotrichum gloeosporioides, and occasionally by C. karstii. Consistently with the results of this study, both C. gloeosporioides and C. karstii were found to be associated with the disease in Central Valley in California, but the proportion and distribution of the two Colletotrichum species in citrus groves of California, Albania and Italy were different. In Albania and Italy, winds and drought were identified as the stress factors predisposing the host-plant to the infections by Colletotrichum spp. and allowing these ubiquitous fungi to switch from a endophytic or saprophytic to a pathogenic lifestyle, while in California the predisposing stress factors have not yet been precisely determined [5,52]. A better understanding of both the diversity of Colletotrichum species, associated with twig and shoot dieback of citrus, and the factors triggering the outbreaks of this disease is basilar for developing effective management strategies. In California, the effectiveness of chemical treatments with fungicides, including strobilurins (azoxystrobin, pyraclostrobin and trifloxystrobin), triazoles (fenbuconazole) and copper fungicides, are being investigated as part of an integrated disease management strategy. A more sustainable management strategy, compatible with organic farming, should privilege measures aimed at both preventing or mitigating the effect of predisposing factors and reducing the amount of inoculum of Colletotrichum in the orchard, such as proper management of the irrigation to avoid water stress, use of windbreaks to protect the trees from winds and pruning to remove withered twigs and branches and stimulate new vegetation flushing.
Author Contributions
Conceptualization, S.O.C., A.P. and M.C.; methodology, A.P., S.O.C., M.R. and F.A.; software, F.A. and M.R.; validation, S.O.C., A.P. and M.C.; formal analysis, F.A. and M.R.; investigation, M.R., F.A. and A.P.; resources, S.O.C., A.P. and M.C.; data curation, F.A. and M.R.; writing—original draft preparation, F.A. and M.R.; writing—review and editing, S.O.C., A.P. and M.C.; visualization, S.O.C.; supervision, S.O.C., A.P. and M.C.; project administration, S.O.C. and A.P.; funding acquisition, S.O.C., A.P. and M.C. All authors have read and agreed to the published version of the manuscript.
Funding
This research was funded by the University of Catania, Italy “Investigation of phytopathological problems of the main Sicilian productive contexts and eco-sustainable defense strategies (MEDIT-ECO)” PiaCeRi - PIAno di inCEntivi per la Ricerca di Ateneo 2020-22 linea 2” “5A722192155 ”; “F.A. has been granted a Ph.D. fellowship “Scienze Agrarie, Alimentari, Forestali e Ambientali—XXXIII cycle”, University of Palermo; M.R. has been granted a fellowship by CREA “OFA” (Rende, Italy), this study is part of his activity as PhD, in “Agricultural, Food, and Forestry Science”, University Mediterranean of Reggio Calabria, XXXV cycle”.
Institutional Review Board Statement
Not pertinent.
Informed Consent Statement
Not pertinent.
Data Availability Statement
Not pertinent.
Acknowledgments
The authors are grateful to Jordan Merkuri, “Didactic and Scientific Research Center—Durres, Albania” for his help in isolating the pathogen; and to V. Lo Giudice for the encouragement to focus on this emerging phytopathological problem of citrus; the authors wish also to thank Anna Davies for the English revision of the text and G. Gozzo for providing assistance during the collection of samples.
Conflicts of Interest
The authors declare no conflict of interest. The funders had no role in the design of the study; in the collection, analyses, or interpretation of data; in the writing of the manuscript, or in the decision to publish the results.
References
- Shkreli, E.; Imami, D. Citrus Sector Study; ASF Project Office: Tiranë, Albania, 2019. [Google Scholar]
- Istat.it. Available online: http://dati.istat.it/Index.aspx?QueryId=33705 (accessed on 18 September 2020).
- Sinab.it. Available online: http://www.sinab.it/node/22428 (accessed on 18 September 2020).
- Cacciola, S.O.; Gullino, M.L. Emerging and re-emerging fungus and oomycete soil-borne plant diseases in Italy. Phytopathol. Mediterr. 2019, 58, 451–472. [Google Scholar]
- Mayorquin, J.S.; Nouri, M.T.; Peacock, B.B.; Trouillas, F.P.; Douhan, G.W.; Kallsen, C.; Eskalen, A. Identification, Pathogenicity, and Spore Trapping of Colletotrichum karstii Associated with Twig and Shoot Dieback in California. Plant Dis. 2019, 103, 1464–1473. [Google Scholar] [CrossRef] [PubMed]
- Eskalen, A.; Dohuan, G.W.; Craig, K.; Mayorquin, J.S. Colletotrichum dieback of mandarins and Navel oranges in California: A new twig and shoot disease in the Central Valley. Citrograph 2019, 10, 50–54. [Google Scholar]
- Benyahia, H.; Ifia, A.; Smaili, C.; Afellah, M.; Lamsetef, Y.; Timmer, L.W.; Ifi, A. First report of Colletotrichum gloeosporioides causing withertip on twigs and tear stain on fruit of citrus in Morocco. Plant Pathol. 2003, 52, 798. [Google Scholar] [CrossRef]
- Rhaiem, A.; Taylor, P.W.J. Colletotrichum gloeosporioides associated with anthracnose symptoms on citrus, a new report for Tunisia. Eur. J. Plant Pathol. 2016, 146, 219–224. [Google Scholar] [CrossRef]
- Mahiout, D.; Bendahmane, B.S.; Youcef Benkada, M.; Mekouar, H.; Berrahal, N.; Rickauer, M. First report of Colletotrichum gloeosporioides on citrus in Algeria. Phytopathol. Mediterr. 2018, 57, 355–359. [Google Scholar]
- Ramos, A.P.; Talhinhas, P.; Sreenivasaprasad, S.; Oliveira, H. Characterization of Colletotrichum gloeosporioides, as the main causal agent of citrus anthracnose, and C. karstii as species preferentially associated with lemon twig dieback in Portugal. Phytoparasitica 2016, 44, 549–561. [Google Scholar] [CrossRef]
- Dowling, M.; Peres, N.; Villani, S.; Schnabel, G. Managing Colletotrichum on fruit crops: A “complex” challenge. Plant Dis. 2020, 104, 2301–2316. [Google Scholar] [CrossRef]
- Brown, A.E.; Sreenivasaprasad, S.; Timmer, L.W. Molecular characterization of slow-growing orange and key lime anthracnose strains of Colletotrichum from citrus as C. acutatum. Phytopathology 1996, 86, 523–527. [Google Scholar] [CrossRef]
- Peres, N.A.; Timmer, L.W.; Adaskaveg, J.E.; Correll, J.C. Lifestyles of Colletotrichum acutatum. Plant Dis. 2005, 89, 784–796. [Google Scholar] [CrossRef]
- Damm, U.; Cannon, P.; Woudenberg, J.; Johnston, P.; Weir, B.; Tan, Y.; Shivas, R.; Crous, P. The Colletotrichum boninense species complex. Stud. Mycol. 2012, 73, 1–36. [Google Scholar] [CrossRef] [PubMed]
- Bragança, C.A.; Damm, U.; Baroncelli, R.; Júnior, N.S.M.; Crous, P.W. Species of the Colletotrichum acutatum complex associated with anthracnose diseases of fruit in Brazil. Fungal Biol. 2016, 120, 547–561. [Google Scholar] [CrossRef]
- Savi, D.C.; Rossi, B.J.; Rossi, G.R.; Ferreira-Maba, L.S.; Bini, I.H.; Trindade, E.D.S.; Goulin, E.H.; Machado, M.A.; Glienke, C. Microscopic analysis of colonization of Colletotrichum abscissum in citrus tissues. Microbiol. Res. 2019, 226, 27–33. [Google Scholar] [CrossRef]
- Guarnaccia, V.; Groenewald, J.; Polizzi, G.; Crous, P. High species diversity in Colletotrichum associated with citrus diseases in Europe. Persoonia 2017, 39, 32–50. [Google Scholar] [CrossRef] [PubMed]
- Moges, A.; Belew, D.; Admassu, B.; Yesuf, M.; Maina, S.; Ghimire, S. Frequent association of Colletotrichum species with citrus fruit and leaf spot disease symptoms and their genetic diversity in Ethiopia. J. Plant Pathol. Microbiol. 2017, 8. [Google Scholar] [CrossRef]
- Ben Hadj Daoud, H.; Baraldi, E.; Iotti, M.; Leonardi, P.; Boughalleb-M’Hamdi, N. Characterization and pathogenicity of Colletotrichum spp. causing citrus anthracnose in Tunisia. Phytopathol. Mediterr. 2019, 58, 175–185. [Google Scholar]
- Uysal, A.; Kurt, Ş. First report of Colletotrichum karstii causing anthracnose on citrus in the Mediterranean region of Turkey. J. Plant Pathol. 2019, 101, 753. [Google Scholar] [CrossRef]
- Lima, W.G.; Spósito, M.B.; Amorim, L.; Gonçalves, F.P.; De Filho, P.A.M. Colletotrichum gloeosporioides, a new causal agent of citrus post-bloom fruit drop. Eur. J. Plant Pathol. 2011, 131, 157–165. [Google Scholar] [CrossRef]
- Damm, U.; Cannon, P.; Woudenberg, J.; Crous, P. The Colletotrichum acutatum species complex. Stud. Mycol. 2012, 73, 37–113. [Google Scholar] [CrossRef]
- Weir, B.; Johnston, P.; Damm, U. The Colletotrichum gloeosporioides species complex. Stud. Mycol. 2012, 73, 115–180. [Google Scholar] [CrossRef]
- Peng, L.; Yang, Y.; Hyde, K.D.; Bahkali, A.H.; Liu, Z. Colletotrichum species on Citrus leaves in Guizhou and Yunnan provinces, China. Cryptogam. Mycol. 2012, 33, 267–283. [Google Scholar]
- Huang, F.; Chen, G.Q.; Hou, X.; Fu, Y.S.; Cai, L.; Hyde, K.D.; Li, H.Y. Colletotrichum species associated with cultivated citrus in China. Fungal Divers. 2013, 61, 61–74. [Google Scholar] [CrossRef]
- Schena, L.; Mosca, S.; Cacciola, S.O.; Faedda, R.; Sanzani, S.M.; Agosteo, G.E.; Sergeeva, V.; Magnano di San Lio, G. Species of the Colletotrichum gloeosporioides and C. boninense complexes associated with olive anthracnose. Plant Pathol. 2014, 63, 437–446. [Google Scholar] [CrossRef]
- Aiello, D.; Carrieri, R.; Guarnaccia, V.; Vitale, A.; Lahoz, E.; Polizzi, G. Characterization and Pathogenicity of Colletotrichum gloeosporioides and C. karstii Causing Preharvest Disease on Citrus sinensis in Italy. J. Phytopathol. 2015, 163, 168–177. [Google Scholar] [CrossRef]
- Taheri, H.; Javan-Nikkhah, M.; Elahinia, S.A.; Khodaparast, S.A.; Golmohammadi, M. Species of Colletotrichum associated with citrus trees in Iran. Mycol. Iran. 2016, 3, 1–14. [Google Scholar]
- Faedda, R.; Agosteo, G.E.; Schena, L.; Mosca, S.; Frisullo, S.; Magnano Di San Lio, G.; Cacciola, S.O. Colletotrichum clavatum sp. nov. identified as the causal agent of olive anthracnose in Italy. Phytopathol. Mediterr. 2011, 50, 283–302. [Google Scholar]
- Cacciola, S.O.; Gilardi, G.; Faedda, R.; Schena, L.; Pane, A.; Garibaldi, A.; Gullino, M.L. Characterization of Colletotrichum ocimi Population Associated with Black Spot of Sweet Basil in Northern Italy. Plants 2020, 9, 654. [Google Scholar] [CrossRef]
- ChromasPro v. 1.5 Software. Available online: http://www.technelysium.com.au/ (accessed on 15 October 2020).
- Shivas, R.G.; Tan, Y.P. A taxonomic re-assesment of Colletotrichum acutatum, introducing C. fioriniae comb. at stat. nov. and C. simmondsii sp. nov. Fungal Divers. 2009, 39, 111–112. [Google Scholar]
- Uematsu, S.; Kageyama, K.; Moriwaki, J.; Sato, T. Colletotrichum carthami comb. nov., an anthracnose pathogen of safflower, garland chrysanthemum and pot marigold, revived by molecular phylogeny with authentic herbarium specimens. J. Gen. Plant Pathol. 2012, 78, 316–330. [Google Scholar] [CrossRef]
- Lubbe, C.M.; Denman, S.; Cannon, P.F.; Groenewald, J.Z.; Lamprecht, S.C.; Crous, P.W. Characterization of Colletotrichum Species Associated with Diseases of Proteaceae. Mycologia 2004, 96, 1268–1279. [Google Scholar] [CrossRef]
- Yang, Y.; Cal, L.; Yu, Z.; Liu, Z.; Hyde, K.D. Colletotrichum species on Orchidaceae in Southwest China. Cryptogam. Mycol. 2011, 32, 229–253. [Google Scholar]
- Cannon, P.F.; Damm, U.; Johnston, P.R.; Weir, B.S. Colletotrichum—Current status and future directions. Stud. Mycol. 2012, 73, 181–213. [Google Scholar] [CrossRef]
- TOPALi v2. Available online: http://www.topali.org/ (accessed on 15 October 2020).
- Freeman, S.; Katan, T.; Shabi, E. Characterization of Colletotrichum Species Responsible for Anthracnose Diseases of Various Fruits. Plant Dis. 1998, 82, 596–605. [Google Scholar] [CrossRef]
- R Core Team. R: A Language and Environment for Statistical Computing; R Foundation for Statistical Computing: Vienna, Austria, 2018; Available online: https://www.R-project.org (accessed on 18 October 2020).
- Timmer, L.W.; Brown, G.E. Biology and control of anthracnose diseases of citrum. In Host Specificity; Prusky, D., Freeman, S., Dickman, M.B., Eds.; The American Phytopathological Society: St. Paul, MN, USA, 2000; pp. 300–316. [Google Scholar]
- Phoulivong, S.; Cai, L.; Chen, H.; McKenzie, E.H.C.; Abdelsalam, K.; Chukeatirote, E.; Hyde, K.D. Colletotrichum gloeosporioides is not a common pathogen on tropical fruits. Fungal Divers. 2010, 44, 33–43. [Google Scholar] [CrossRef]
- Douanla-Meli, C.; Unger, J.-G. Phylogenetic study of the Colletotrichum species on imported citrus fruits uncovers a low diversity and a new species in the Colletotrichum gigasporum complex. Fungal Biol. 2017, 121, 858–868. [Google Scholar] [CrossRef]
- Abdelfattah, A.; Nicosia, M.G.L.D.; Cacciola, S.O.; Droby, S.; Schena, L. Metabarcoding Analysis of Fungal Diversity in the Phyllosphere and Carposphere of Olive (Olea europaea). PLoS ONE 2015, 10, e0131069. [Google Scholar] [CrossRef] [PubMed]
- Peres, N.A.; MacKenzie, S.J.; Peever, T.L.; Timmer, L.W. Postbloom Fruit Drop of Citrus and Key Lime Anthracnose Are Caused by Distinct Phylogenetic Lineages of Colletotrichum acutatum. Phytopathology 2008, 98, 345–352. [Google Scholar] [CrossRef]
- Mosca, S.; Nicosia, M.G.L.D.; Cacciola, S.O.; Schena, L. Molecular Analysis of Colletotrichum Species in the Carposphere and Phyllosphere of Olive. PLoS ONE 2014, 9, e114031. [Google Scholar] [CrossRef] [PubMed]
- Schena, L.; Abdelfattah, A.; Mosca, S.; Nicosia, M.G.L.D.; Agosteo, G.E.; Cacciola, S.O. Quantitative detection of Colletotrichum godetiae and C. acutatum sensu stricto in the phyllosphere and carposphere of olive during four phenological phases. Eur. J. Plant Pathol. 2017, 149, 337–347. [Google Scholar] [CrossRef]
- Pangallo, S.; Nicosia, M.G.L.D.; Agosteo, G.E.; Abdelfattah, A.; Romeo, F.V.; Cacciola, S.O.; Rapisarda, P.; Schena, L. Evaluation of a Pomegranate Peel Extract as an Alternative Means to Control Olive Anthracnose. Phytopathology 2017, 107, 1462–1467. [Google Scholar] [CrossRef] [PubMed]
- Crous, P.W.; Groenewald, J.Z.; Slippers, B.; Wingfield, M.J. Global food and fibre security threatened by current inefficiencies in fungal identification. Philos. Trans. R. Soc. B Biol. Sci. 2016, 371, 20160024. [Google Scholar] [CrossRef] [PubMed]
- Yaseen, T.; D’Onghia, A. Fusarium spp. Associated to citrus dry root rot: An emerging issue for mediterranean citriculture. Acta Hortic. 2012, 940, 647–655. [Google Scholar] [CrossRef]
- Adesemoye, A.; Eskalen, A.; Faber, B.; Bender, G.; Connell, N.O.; Kallsen, C.; Shea, T. Current knowledge on Fusarium dry rot of citrus. Citrograph 2011, 2, 29–33. [Google Scholar]
- Sandoval-Denis, M.; Guarnaccia, V.; Polizzi, G.; Crous, P. Symptomatic Citrus trees reveal a new pathogenic lineage in Fusarium and two new Neocosmospora species. Persoonia 2018, 40, 1–25. [Google Scholar] [CrossRef] [PubMed]
- Li, T.; Fan, P.; Yun, Z.; Jiang, G.; Zhang, Z.; Jiang, Y. β-Aminobutyric Acid Priming Acquisition and Defense Response of Mango Fruit to Colletotrichum gloeosporioides Infection Based on Quantitative Proteomics. Cells 2019, 8, 1029. [Google Scholar] [CrossRef] [PubMed]
Publisher’s Note: MDPI stays neutral with regard to jurisdictional claims in published maps and institutional affiliations. |
© 2021 by the authors. Licensee MDPI, Basel, Switzerland. This article is an open access article distributed under the terms and conditions of the Creative Commons Attribution (CC BY) license (http://creativecommons.org/licenses/by/4.0/).












